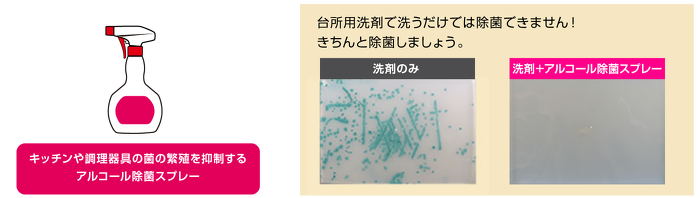

サラヤ微生物研究センター
サラヤ微生物研究センターは、2009年に微生物学的評価を専門に行う部隊として設立されました。
本センターでは、微生物取扱いのプロがウイルス不活化試験や殺菌力試験などを実施し、信頼性・再現性の高いエビデンスデータを提供しています。また評価を行う中で、新たな評価方法の確立やお客様目線の分かりやすいデータ取得法の考案も行っています。さらに薬剤の作用機序の解明や新規微生物の培養などの基礎研究にも取り組んでいます。
微生物の取扱いに特化したメンバー構成
サラヤ微生物研究センターは微生物の取扱いに特化したメンバーで構成されており、独自の教育訓練をクリアした研究員が微生物試験を行っています。数百株にもおよぶウイルス・細菌を保有しており、試験に応じて必要な微生物を培養・評価しております。
標準法による信頼性の高い評価
サラヤ微生物研究センターでは早くから国際的な標準試験法を取り入れ、世界に通用するエビデンスデータ取得に取り組んでいまいりました。訓練された研究員が標準試験法に則った厳格な評価を行うことで、信頼性・再現性の高いエビデンスデータを提供しています。
標準試験法例
- 欧州標準化委員会(CEN)の欧州標準試験法(EN試験法)
- 米国材料試験協会のASTM試験法
- ドイツのロベルトコッホ研究所(RKI)およびドイツウイルス疾病管理試験協会(DVV)のDVV&RKIガイドライン
また、得られた研究成果は論文発表、学会発表を通じて積極的に発信しています。
お客様目線の評価系の構築
標準法に準拠した評価だけではなく、独自にお客様目線の評価系を構築することにも力を入れています。(1)ウイルスを用いた手洗い評価、(2)ノロウイルス代替ウイルスを用いた嘔吐物処理の評価、(3)ウエットワイパー製品のふき取り評価など、製品を使用する状況を想定した評価系を考案し、使用効果をより分かりやすくお伝えすることに取り組んでいます。これらは独自の評価系ではありますが、科学的に深化させ、論文・学会発表を行うなどして、学術的にも認められた内容となっています。
- 日本防菌防黴学会 第45回年次大会「手洗いによるウイルス除去および不活化効果の検証」
- 日本防菌防黴学会 第44回年次大会「ノロウイルス代替ウイルスを用いた嘔吐物処理方法の検証」(ポスター賞受賞)
- 中村絵美ら. "環境清拭用クロスの微生物に対する性能評価." 日本環境感染学会誌 31.2 (2016): 100-106.
例1:サラヤの推奨する衛生的手洗いによる手に付着したウイルスの除去効果の検証
例2:ノロウイルス代替ウイルスを用いた嘔吐物処理方法の検討
共感できるデータの提供
数値による学術的データを取得するだけではなく、お客様にとって共感できる臨場感のあるデータの表現にもこだわっています。例えば、握ったおにぎりを4℃と30℃で1日保存した場合、一見すると何も変化がないように見えますが、ブラックライトを当てると30℃で保存したおにぎりが緑色に光ります。これは、ブラックライトに当たると光る特殊な細菌を使用することで、常温で保存すると細菌が繁殖してしまうことを視覚的に示しています。
この他にも様々な目で見て分かりやすいデータを取得しています。
例1:シリコン部材に生えた頑固なカビの根にカビ除去クリーナーを作用させた様子
例2:使用後のまな板を洗浄+アルコールスプレーしたときの様子
トピックス
新型コロナウイルスを用いた有効性評価
2020年4月から大阪大学微生物病研究所と共同研究契約を締結し、ホンモノである新型コロナウイルスを用いた有効性評価を行っています。国際的な標準法であるEN14476に則って、実使用に近しい環境下での有効性を検証しております。取得した高度なエビデンスに基づき、新型コロナウイルス感染症における対策の構築・提案・普及を行うことで、感染予防および感染者数の拡大防止に貢献すべく、当センターの研究員がBSL-3対応の特別な施設で実験をおこなっております。
手足口病原因ウイルスを用いた除去効果評価
手足口病原因ウイルスを手に付着させ、手洗い石けんおよび酸性アルコール手指消毒剤を用いた手洗い試験を行い、手からウイルスの除去効果を評価しました。
手洗い石けんを用いた手洗いによって、多くのウイルスが除去できていました。(グラフ青)
手洗い石けんで完全には除去できなかったウイルスを、酸性アルコール手指消毒剤の使用によって検出限界以下にまで落とすことができました。(グラフ赤)
よって、手洗い後、酸性アルコール手指消毒剤を使用することでさらなる効果が期待できます。
当社製品を用いた検証結果
<洗って・ふいて・消毒 >
サラヤ微生物研究センターでは、以上のような活動を通して感染症対策の構築・提案・普及を行い、衛生の向上に貢献していきます。